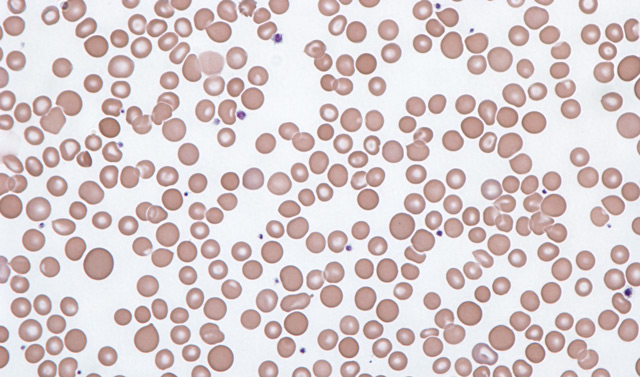

Физиологические нормы красных клеток крови
Существует устоявшаяся практика, когда медики и пациенты называют эритроциты клетками, хотя это определение не совсем корректно. Тем не менее, такое название прочно укоренилось в языке, и нет смысла менять общепринятые термины.
Перед тем как перейти к обсуждению эритроцитарного индекса, стоит ответить на часто возникающий вопрос: что означает диагноз анизоцитоз у детей? Родители могут испытывать тревогу, увидев незнакомое слово в анализах крови своего ребенка. Однако этот медицинский термин не имеет различий между анализами крови у детей и взрослых. У детей чаще наблюдается анизоцитоз с преобладанием микроцитов, что может указывать на развитие железодефицитной анемии, характерной для детского и подросткового возраста. В остальном же все аналогично, поэтому в дальнейшем описании акцент не будет сделан на возрастные особенности.
Эритроциты — это форменные элементы крови, безъядерные тельца, имеющие круглую или слегка овальную форму, напоминающую двояковогнутые диски. Такая форма необходима для увеличения площади поверхности, что способствует эффективному газообмену.
Нормальный диаметр эритроцитов колеблется в пределах 7–8 микрон, а физиологический диапазон этого показателя составляет 5,5–9,5 микрон (графически это отображается кривой Прайс-Джонса). Средний объем эритроцитов находится в диапазоне 80–100 фемтолитров (или кубических микронов) — это значение соответствует норме MCV. Эритроциты с такими параметрами называются нормоцитами, и подавляющее большинство красных кровяных телец должно относиться именно к этой категории.
Расчет эритроцитарных индексов, входящих в общий анализ крови (гемограмма), таких как МСН (среднее содержание гемоглобина), МСНС (средняя концентрация гемоглобина в эритроците), MCV (средний объем эритроцитов) и показатель гетерогенности (разнородности) красных кровяных телец по объему (степень анизоцитоза эритроцитов – RDW), в настоящее время осуществляется с помощью автоматических гематологических анализаторов. Нормальные значения RDW (или анизоцитоза эритроцитов) составляют от 11,5% до 14,5%.
Анизоцитоз в общем анализе крови может быть вызван различными дефицитными состояниями (недостаток витамина В12, фолиевой кислоты, железа), злокачественными опухолями, осложнениями после переливаний крови (иммунные реакции), нарушениями кроветворения в костном мозге, хроническими инфекциями или сердечными заболеваниями (например, ишемической болезнью сердца).
Анизоцитоз — это состояние, характеризующееся наличием в крови эритроцитов различного размера. В норме размеры красных кровяных клеток должны быть однородными, однако при анизоцитозе наблюдается отклонение от этого показателя. Врачи выделяют несколько видов анизоцитоза: микроцитоз (уменьшение размеров клеток), макроцитоз (увеличение) и анизоцитоз смешанного типа. Нормальные размеры эритроцитов варьируются в пределах 6-8 мкм. Появление анизоцитоза может указывать на различные заболевания, такие как анемия, дефицит витаминов или нарушения в работе костного мозга. Важно отметить, что анизоцитоз сам по себе не является диагнозом, а служит сигналом для дальнейшего обследования и выявления основной причины изменения размеров эритроцитов. Врачи подчеркивают необходимость комплексного подхода к анализу крови для точной диагностики и назначения адекватного лечения.

Анизоцитоз эритроцитов
При различных анемиях размеры и объемы кровяных клеток могут значительно изменяться, что приводит к образованию разнородной популяции эритроцитов. Это разнообразие клеток помогает в дифференциальной диагностике анемий. В крови, помимо нормоцитов, можно обнаружить аномальные эритроциты различных размеров, что свидетельствует о гетерогенности популяции красных клеток:
- Значительно увеличенные, огромные, «раздутые» – мегалобласты (диаметр этих клеток превышает 9,5 мкм);
- Немного меньшие по размеру, чем мегалобласты, но больше нормоцитов – макроциты;
- Маленькие форменные элементы (клеточки-лилипуты) – микроциты.
Современные гематологические анализаторы, предназначенные для оценки клеточного состава периферической крови, определяют степень анизоцитоза эритроцитов с помощью формулы, основанной на коэффициенте вариации среднего объема красных кровяных телец (MCV):
- RDW(%) = SD/MCV(фл) х 100%,
где SD – стандартное отклонение объема эритроцитов, а MCV – средний объем эритроцитов.
С внедрением гематологических анализирующих систем в лабораторную практику стало очевидно, что случаи, когда показатель оказывается пониженным, не встречаются. Если же он все-таки ниже нормы, это указывает на возможные проблемы с автоматическим анализатором. В таком случае персоналу необходимо провести калибровку оборудования для получения точных результатов анизоцитоза в общем анализе крови. Пациенту следует повторно обратиться в лабораторию, чтобы избежать лишних волнений.
| Показатель | Норма в анализе крови | О чем говорит отклонение от нормы |
|---|---|---|
| Анизоцитоз (RDW) | 11.5-14.5% | Повышение RDW указывает на наличие анизоцитоза, свидетельствуя о разнообразии размеров эритроцитов. Может указывать на дефицит железа, В12 или фолиевой кислоты, талассемию, анемию хронических заболеваний, миелодиспластический синдром, после химиотерапии. Снижение RDW встречается реже и может быть связано с некоторыми видами анемий. |
| Виды анизоцитоза | Макроцитоз (увеличенные эритроциты), микроцитоз (уменьшенные эритроциты), нормоцитоз (нормальные эритроциты) | Тип анизоцитоза помогает сузить круг возможных причин. Например, макроцитоз часто ассоциируется с дефицитом витамина В12 или фолиевой кислоты, а микроцитоз – с дефицитом железа или талассемией. |
| Клиническая картина (в дополнение к анализу крови) | Утомляемость, слабость, бледность кожи, одышка, головокружение, тахикардия | Эти симптомы, в сочетании с анизоцитозом в анализе крови, указывают на необходимость дальнейшего обследования для выявления причины анемии или другого заболевания крови. |
Глаза врача – незаменимы
Хотя современные анализаторы обладают высокой «умностью», они не могут заменить специалистов в области лабораторной диагностики, которые выполняют гематологические исследования. Лаборант, работая с образцом, одновременно подготавливает мазок для исследования с помощью микроскопа и визуальной оценки врача, чтобы определить степень анизоцитоза эритроцитов.
Если в мазке наблюдаются клетки одинакового размера (нормоциты), анизоцитоз в бланке гемограммы не фиксируется. Этот показатель указывается только в случае, если аномальные эритроциты занимают значительную часть мазка. Если врач обнаруживает мелкие клетки, он отмечает анизоцитоз с преобладанием микроцитов, а если крупные – фиксирует макроцитоз.
Существует также смешанный анизоцитоз, когда до 50% поля мазка занимают аномальные клетки, и неясно, какие из них преобладают: мегалобласты и макроциты (что может указывать на дефицит витамина В12, недостаток фолиевой кислоты или пернициозную анемию) или микроциты (что может свидетельствовать о железодефицитной анемии). В таких случаях врач указывает на смешанный анизоцитоз в бланке анализа, привлекая внимание лечащего врача для назначения дополнительных исследований.
Важно отметить, что в некоторых случаях врач лабораторной диагностики может вернуться к графическому представлению данных, например, к кривой Прайс-Джонса.
Термин «степень анизоцитоза эритроцитов» подразумевает различие по уровням:
- Незначительный анизоцитоз – аномальные клетки занимают до 25% мазка, результат обозначается одним плюсом (+);
- Умеренный анизоцитоз – аномальные клетки составляют до 50% от общего количества, результат: ++;
- Выраженный анизоцитоз – до 75% всех эритроцитов составляют измененные клетки, результат: +++;
- Высокая (острая) степень анизоцитоза – аномальные клетки занимают почти все поле (до 100%), результат обозначается четырьмя плюсами (++++).
Несмотря на сложность ситуации, не стоит сопоставлять кривую Прайс-Джонса и гистограмму, полученную от анализатора, так как первая отражает распределение величин, а вторая – совершенно иные параметры. Эти два метода имеют свои особенности и отличия.
Анизоцитоз — это состояние, характеризующееся наличием в крови эритроцитов различного размера. В норме красные кровяные клетки имеют схожие размеры, но при анизоцитозе наблюдается их значительное разнообразие. В анализе крови это может проявляться в виде увеличения индекса анизоцитоза. Причинами данного состояния могут быть анемия, дефицит витаминов, хронические заболевания или нарушения в работе костного мозга. В зависимости от размеров клеток различают микроцитарный и макроцитарный анизоцитоз. Микроциты указывают на железодефицитную анемию, тогда как макроциты могут свидетельствовать о дефиците витамина B12 или фолиевой кислоты. Важно учитывать, что анизоцитоз сам по себе не является диагнозом, а лишь симптомом, требующим дальнейшего обследования для выявления основной причины.

Анизоцитоз эритроцитов и диагностика анемий
Оценка размеров эритроцитов и расчет эритроцитарных индексов важны для диагностики анемий, так как отражают состояние кроветворения в костном мозге (эритропоэз). Показатель анизоцитоза помогает выделить различные типы анемий и определить их характер:
- Увеличение числа макроцитов указывает на молодость и незрелость красных кровяных клеток, что часто связано с дефицитом витамина В12, фолиевой кислоты или других факторов, необходимых для нормального кроветворения.
- Преобладание микроцитов, то есть наличие большого количества мелких клеток, может свидетельствовать о том, что эритропоэз направлен на образование микронормобластов. Это происходит при недостатке железа в организме (железодефицитная анемия) или других специфических компонентов.
- Нормальные показатели анизоцитоза не всегда означают отсутствие заболеваний. Это может наблюдаться, например, при апластической анемии или анемиях, связанных с хроническими заболеваниями.
Важно отметить, что наличие однородной популяции клеток, даже с уменьшенным объемом (микроциты), обычно не влияет на показатель RDW, который остается в пределах нормы. Поэтому в таких случаях дополнительно учитывают значение другого индекса – MCV, что позволяет проводить дифференциальную диагностику микроцитарных анемий.
Для более полной оценки состояния красной крови данные о анизоцитозе, полученные от анализатора в цифровом формате, сопоставляют с гистограммой, показывающей частоту встречаемости клеток различных объемов.
Анизоцитоз тромбоцитов
Современные автоматизированные гематологические системы обладают широкими возможностями. Они определяют различные показатели крови, такие как количество эритроцитов и лейкоцитов, уровень гемоглобина и гематокрита, а также эритроцитарные индексы и лейкоцитарную формулу. Эти устройства также подсчитывают тромбоциты, что требует отдельной окраски при ручном анализе. Кроме того, они рассчитывают тромбоцитарные индексы и показатель анизоцитоза тромбоцитов (PDW).
В автоматических анализаторах для подсчета тромбоцитов используется один канал с эритроцитами. Это делает необходимым наличие специальной системы электронных дискриминаторов, которые позволяют различать:
- Макротромбоциты;
- Микроэритроциты;
- Шизоциты (фрагменты эритроцитов);
- Клеточный мусор (остатки цитоплазмы лейкоцитов).
PDW — показатель анизоцитоза тромбоцитов, который в норме колеблется от 14 до 20%. В сочетании с другими тромбоцитарными индексами (РСТ, P-LCP) он не имеет значительного диагностического значения. Наибольшее количество информации можно получить из гистограммы распределения тромбоцитов.
Увеличение показателя анизоцитоза тромбоцитов может указывать на миелопролиферативные процессы. Снижение PDW наблюдается при некоторых формах лейкозов, апластической анемии, ДВС-синдроме, тяжелых заболеваниях печени и других состояниях.
Перейти в раздел:
- Кровь и её заболевания, компоненты, анализы, биохимия
Рекомендации для читателей СосудИнфо предоставляют профессиональные медики с высшим образованием и опытом работы в данной области.

Вопрос-ответ
О чем говорит анизоцитоз в анализе крови?
Анизоцитоз (различие в размерах эритроцитов) – это не самостоятельное заболевание, а лабораторный признак, указывающий на нарушения в работе кроветворной системы.
Вызывает ли лейкемия анизоцитоз?
Дефицит витамина B12, фолиевой кислоты (B9) или железа может привести к анизоцитозу. Может ли лейкемия вызывать анизоцитоз? Лейкемия может привести к анемии, которая является известной причиной анизоцитоза. Некоторые ранние исследования на старых крысах показали, что у крыс с запущенной стадией лейкемии часто наблюдался анизоцитоз.
Кто лечит анизоцитоз?
Анизоцитоз – выбрать лечащего врача. Гематолог – это врач, который специализируется на заболеваниях крови. Это значит, что на консультацию к гематологу нужно обязательно идти с результатом анализа крови.
Что такое анизохромия в анализе крови?
Различная окраска отдельных эритроцитов в мазке крови носит название анизохромия. Наблюдается при постгеморрагических анемиях, нередко при железодефицитных анемиях. Важное диагностическое значение имеет не только изменение размера, но и формы эритроцитов.
Советы
СОВЕТ №1
Обратите внимание на результаты анализа крови. Если у вас обнаружен анизоцитоз, важно не игнорировать это состояние. Обсудите результаты с врачом, чтобы понять, какие дополнительные исследования могут потребоваться для выяснения причины изменения размеров эритроцитов.
СОВЕТ №2
Следите за своим питанием. Анизоцитоз может быть связан с дефицитом витаминов и минералов, таких как витамин B12 и фолиевая кислота. Убедитесь, что ваш рацион включает достаточное количество этих питательных веществ, чтобы поддерживать здоровье крови.
СОВЕТ №3
Регулярно проходите медицинские обследования. Профилактические анализы крови помогут выявить анизоцитоз на ранней стадии и предотвратить возможные осложнения. Не забывайте о важности регулярного контроля состояния здоровья.
СОВЕТ №4
Обратите внимание на симптомы. Если вы замечаете такие признаки, как усталость, слабость, бледность кожи или учащенное сердцебиение, это может указывать на проблемы с кровью. Не откладывайте визит к врачу для диагностики и лечения.